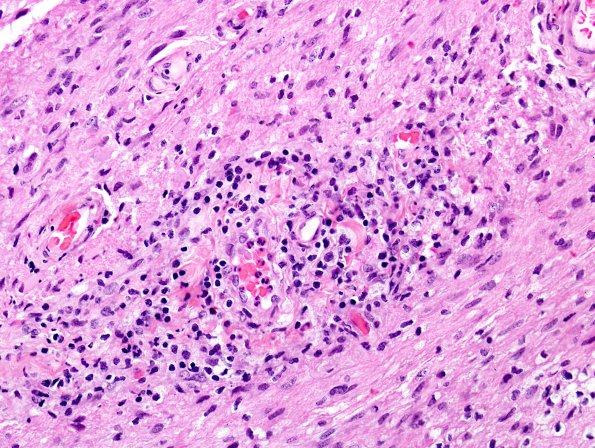
5B4 NMOSD (AANP #7 2009) H&E 4

Table of Contents
Washington University Experience | MYELIN (IMMUNE-MEDIATED) | NMO (Neuromyelitis Optica) | NMO Spectrum Disorder | 5B4 NMOSD (AANP #7 2009) H&E 4
In this case most vessels are surrounded by large numbers of macrophages poised to exit the lesion. However, in this case the vessel is surrounded by inflammatory cells and scattered eosinophils (H&E)